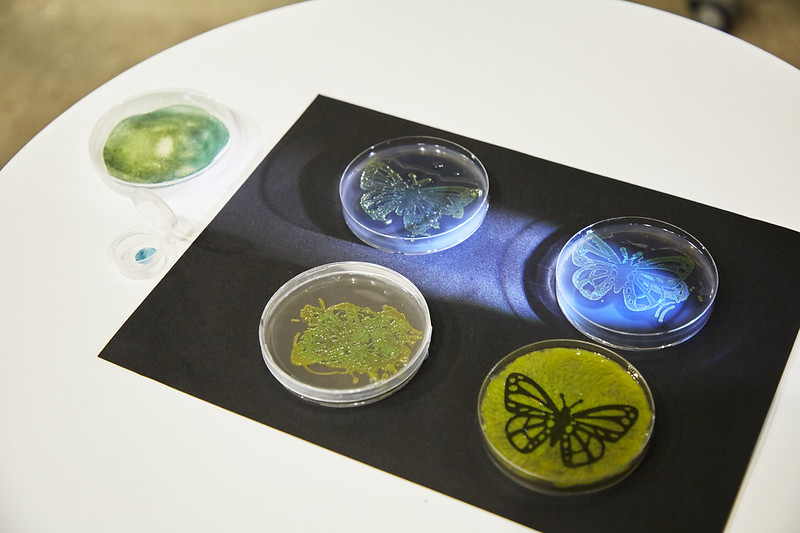

「表現活動を通じた死との向き合い方の提案」100BANCH実験報告会

100BANCHで毎月開催している、若者たちが試行錯誤を重ねながら取り組んできた“未来に向けた実験”を広くシェアするイベント「実験報告会」。
これからの100年をつくるU35の若手リーダーのプロジェクトを推進するアクセラレーションプログラム「GARAGE Program」を終えたプロジェクトによる100BANCHでの活動報告や、100BANCHでの挑戦を経て、プロジェクトを拡大・成長させた先輩プロジェクトによるナビゲータートークを実施しています。
2025年12月23日に開催した実験報告会では、死別の喪失体験をコンセプトにした作品やプロジェクトを通して死との向き合い方を提案し続けているGARAGE Program24期生「PAIN PAIN GO AWAY」の中澤希公をナビゲーターとし、GARAGE Programを終了した5プロジェクトが活動を報告しました。
本レポートではその発表内容をお伝えします。
生きたバクテリアの色彩で、印刷文化の未来を描く
登壇者:杉浦真也
プロジェクト詳細:https://100banch.com/projects/chroma-life-project

「CHROMA LIFE PROJECT」は、生きたバクテリアを「能動的インク」として活用し、人間と非人間の新たな関係性を探ることを通じて、生きた素材で創造の地平を切り拓くプロジェクトです。
杉浦:山を歩いていると水溜まりに虹色の箔みたいなものが浮かんでいることがあるのですが、それを画用紙に転写すると虹色の箔や金箔が得られた経験がありました。この体験と印刷技術を掛け算することで何かできないだろうかと思い、このプロジェクトをはじめました。これまでもバクテリアを使ったインクは多くあり、そのほとんどが化学物質だけが使われていたのですが、私はバクテリア本来の色味、生命の色を探求してきました。バクテリアは構造色本来の色味を出すので、細胞のフィルムの厚さにより、緑やピンク、赤や青というように実際に様々な色味を示しました。私は2、3年前にセメントばかりを触っていた時期があるので、今後はセメントタイルへの染色や、建築や自動車のデザインに導入していくことを考えています。
100BANCHでは、10月は主に資金の確保、11月には実験をするための材料の調達、12月には細かな構造のプリントを行いました。実際にバクテリアのプリントをする上で、今後は私以外でもできるようにしたいと思っていて、型をつくったり、色をコントロールできるアプリケーションを開発しようと考えています。バクテリアのインクは生きた印刷物なので、非現実的なものを現実空間にもたらすことによって、思いがけない発見や出会いがあるのではないかと感じています。
「今後はGARAGE Programを3ヶ月延長し、Epson Innovation Challenge に参加して新しいインクの開発、印刷の開発をしていこうと思っています。」と杉浦は話しました。
リレー×オーディションで、立場を超えた「物語」の共創と熱狂を生み出す!
登壇者:佐々木竜太郎
プロジェクト詳細:https://100banch.com/projects/novel-colony

「Novel Colony」は、参加者が共同で物語を創作するリレー小説形式と公開オーディションのような選抜システムを組み合わせ、様々な人が同時に楽しめる物語を創作する方法の確立を目指すプロジェクトです。
佐々木:「Novel Colony」は集団で物語をつくるプロジェクトです。複数のメンバーが物語の続きを考え、その中から良いものを1つ決めていくという工程を繰り返すことで、立場の違いを乗り越え、誰もが熱狂できるような物語をつくれるのではないかと考えました。
100BANCHでの実験のプロセスは大きく3つに分かれています。最初に、小説家に作品の冒頭部分だけを執筆してもらいます。その続きとなる部分を公募し、多くの人から候補を集め、集まった中から議論と投票を行い、続きとなる物語を1つ選びます。公募と選択のプロセスを繰り返していくことで、誰かがリードしなくても物語がどんどんできていく、自立分散的な構造にしました。その冒頭の執筆について、今回は小説家の舞城王太郎氏にオファーをして執筆していただきました。同時に3つの物語の冒頭を書いてもらい、この続きをどうしていくか、いろんな人と一緒に考えていきました。続きを公募したところ、プロアマ問わず幅広い方が参加してくださり、48点もの物語が集まりました。
11月30日には100BANCHで「編集会議」というタイトルでイベントを開催し、どの物語が良いかという議論をしました。書き手と読み手で分かれて議論と投票を繰り返すのですが、3回の投票を行うことで、議論を通じて選ぶ作品がどのように変わっていったのかを計測できるようにしました。イベントを通してわかったことの1つは、書き手も読み手がその物語についてどのようにういう風に考えたのかを知りたいということでした。また、議論をすることで選択がばらつかず、だんだんと集中していくことが見えてきました。この辺りをもう少し詳しく見ていくことで、合意に至るまでに役立つヒントを見つけられるのではないかと考えています。また、選ばれる作品については、最初に選ばれたものが最後にも選ばれるわけではなくて、途中で話せば話すほど魅力が伝わっていく物語が選ばれるという傾向が見えました。今後、そういった作品の特徴を明らかにしていくことで、物語をつくるときに役立つ知見が得られるのではないかと考えています。

「物語はまだ制作中なのですが、完結後は出版もする予定です。また、データ分析も継続して公式サイトで公開していく予定です。」と佐々木は話しました。
「翻訳できないことば」との出会いから、言葉が人の心に灯る循環を生み出したい
登壇者:友成隼也
プロジェクト詳細:https://100banch.com/projects/kotoha

「kotoha」は、世界中の「翻訳できないことば」を記録・共有するオンラインデータベースの構築や、それが表す感情や状況を体感できる映像作品や企画展、商品の制作を行うことで、言語の多様性と日常の感情をつなぐプロジェクトです。
友成:我々は「言葉が人間の色々な分断を乗り越える」と信じ、世界にある約7,000言語と日本の日常をつなぐ様々な活動を行っています。特に「翻訳のできないことば」に魅力を感じて、まずはそれらを集めるところからはじめました。現在、メンバーの一人がフランスのイナルコ大学で独自のプラットフォームを開発し、世界の「翻訳のできないことば」の収集を行っています。また、自分の感情を入力すると、それにぴったりのことばが出てくるサービスや、企業のブランドネーミングサービスをつくったり、世界のことばを通じたショートドラマのようなものをSNSで発信したりしています。
100BANCHに入居してからの活動では「DOR」という短編映画をつくって、いくつか賞をいただきました。また、現在はMAAHA CHOCOLATEさんと一緒にバレンタインチョコを作っています。「好きという気持ちを世界の言葉でやさしく包んであげることで、恥ずかしくて言えない気持ちをやさしく溶かしてくれる」というもので、1月1日からの販売です。他にもたくさんのコンペに応募したり、色々なメディアに取り上げていただいたりしているのですが、まずは kotoha の存在や「翻訳のできないことば」の存在を世間に知っていただこうということで、色々なところに顔を出してお話させていただいています。2月3日〜9日には「#この気持ちに名前があったら展」という展示を渋谷モディで開催します。世界には恋に関することばがたくさんあるのですが、そういった言葉を通じて、恋や愛についてこれまで言葉にできなかったモヤモヤした感情を解消していただけたらなと思っています。

「将来的には長編の映画制作やいろんなクリエイティブを通じて、翻訳のできない言葉の面白さを知ってもらい、この世界とつながる接点として言葉を起点に新しい社会をつくっていけたらなと思っています。」と友成は話しました。
記憶の主権を人からモノへ。思い出が日常空間に編み込まれる社会を実装する。
登壇者:仲村怜夏
プロジェクト詳細:https://100banch.com/projects/yomiyomi

「yomiyomi」は、「記憶がモノを通して生き続ける世界」を目指すプロジェクトです。
仲村:私たちは、友だちや家族、恋人との時間の中にある忘れたくない瞬間を形に残す「思い出召喚ステッカー」というプロダクトの開発と販売をしています。2025年3月のプレリリース以降、4,000枚以上のステッカーを販売してきました。ただ、私たちはステッカー屋さんになりたいわけではなく、デザインとテクノロジーの力で、記憶や思い出をテーマに様々なプロダクトを生み出し、記憶に新たな意味を与えていくことをビジョンに活動しています。
GARAGE Programは延長して現在6ヶ月目なのですが、今回は入居期間での取り組みを3つに分けてお話しします。1つ目は、退路を断ったことです。3年間勤めた会社を辞め、yomiyomi を法人化しました。100BANCHに入居したときは怖くて会社を辞められなかったのですが、たくさんのトライ&エラーの結果、このテーマに私はすごく情熱を持っているし誰にも譲りたくないということに気づけたので、退路を断つことができました。
2つ目は、TOKYO STARTUP GATEWAY をはじめ、様々なアワードで評価をいただくことができたことです。正直、「出過ぎなんじゃないか」「事業にもっと向き合うべきなんじゃないか」と思った瞬間もあったのですが、結果的には yomiyomi の可能性が広がったと思っています。それまでは知り合いからの紹介がメインでしたが、アワードを通して新しい人たちと出会えたことで色々なコラボレーションが生まれ、それが事業のためになっていることに気づけました。
3つ目は、海外展開の第一歩です。Tokyo Innovation Base の海外出展コースに採択いただき、来月、台湾のTSUTAYA書店でポップアップを開催予定です。この結果からの学びとしては、「夢や理想こそ口に出すべし」ということです。海外に行きたいと繰り返し言っていたことで、このコースを紹介してもらえたり、奇跡的な出来事がすごく多かった1年だったので、このマインドはずっと保ち続けたいです。この6ヶ月間は、本当にたくさん手を動かして、いろんな人に会って種をまき続けたと思います。

「いま、メンバーとあらためて yomiyomi が目指す世界を考えているところです。私は、忘れたくない、忘れられたくない、という人間の根源的な欲求に向き合い続けたいし、それに対する表現が yomiyomi の活動になっていくんだと確信しています。」と仲村は話しました。
障害のある当事者(Need-Knower)の「1の困りごと」から、誰もが快適に過ごせる社会を共創
登壇者:北島未菜
プロジェクト詳細:https://100banch.com/projects/tom-japan

「TOM JAPAN」は、支援機器を共創し、誰もが快適に過ごせる世界の実現を目指すプロジェクトです。
北島:私は元々リハビリ関連の分野を学んでいたのですが、色々な障害があってもなくても、多様な人たちがイノベーションに参画して自分らしい社会をつくれたらいいなと思い、このプロジェクトを行っています。私たちは障害の当事者を「Need-Knower」と呼んでいるのですが、彼らといろんな分野の学生と専門家が一緒になって、社会に変化をもたらすようなムーブメントをつくろうと取り組んでいます。主な活動は、困りごと共有会、アイデアソン、プロダクト開発、コミュニティ形成です。
100BANCHでは、当事者自身が主体的に開発に関わる当事者参加型デザインが大事なのではないかという仮説を立て、大きく4つのことを行ってきました。1つ目として、支援機器の共創のプラットフォームをつくろうというのがあったのですが、自分たちでつくるよりも、すでにあるプラットフォームと連携した方が良いと思い、連携を進めています。2つ目は、東京大学の福祉工学系の研究室と連携してアイデアソンに取り組みました。ニードヒアリングからアイデア出し、プロトタイプ制作、発表という形で、ニーズ収集と可視化を実施していきました。3つ目は、3、4ヶ月前のワークショップで出たアイデアからプロトタイプを開発しました。視覚障害のある弱視の子どもが夜道を歩きたいということで、夜道を明るく照らせるような白杖のプロトタイプを開発し、100BANCHで実証させてもらいました。また、工学部の学生たちに簡単なアンケートをとらせてもらった結果、こういったワークショップの存在は知らなかったけれども実は興味がある人も多いことがわかりました。あとはこの共創・参加型デザインを研究としても価値がある形にしていきたいと思っており、現在、スコーピングレビューも進めています。

「この6ヶ月間の成果として、ワークショップやメーカーさんを通して当事者参加型の価値を伝えられそうだとわかりました。今後は連携を広めていきたいなと思っています。」と北島は話しました。
実験報告会の各発表内容はYouTubeでもご覧いただけます。
CHROMA LIFE PROJECT https://youtu.be/80ruChKNxNU?si=tG3bo6ZFX9K3R_BF
Novel Colony https://youtu.be/gWemFbEu59c?si=EhR2FTLIqR-UkeMa
kotoha https://youtu.be/dYEMzPDJ8CQ?si=hZwMshI_yzs84ZGb
次回の実験報告会は1月22日(木)に開催。ぜひご参加ください!

(撮影:鈴木 渉)

【こんな方にオススメ】
・100BANCHに興味がある
・GARAGE Programに応募したい
・直接プロジェクトメンバーと話してみたい
・建築/まちづくりに興味がある
・AIやテクノロジーに興味がある
【概要】
日程:1月22日(木)
時間:19:00 – 21:30 (開場18:45)
会場:100BANCH 3F
参加費:無料(1ドリンク付き)
参加方法:Peatixでチケットをお申し込みの上、当日100BANCHへお越しください
詳細はこちらをご覧ください:https://100banch.com/events/75760/